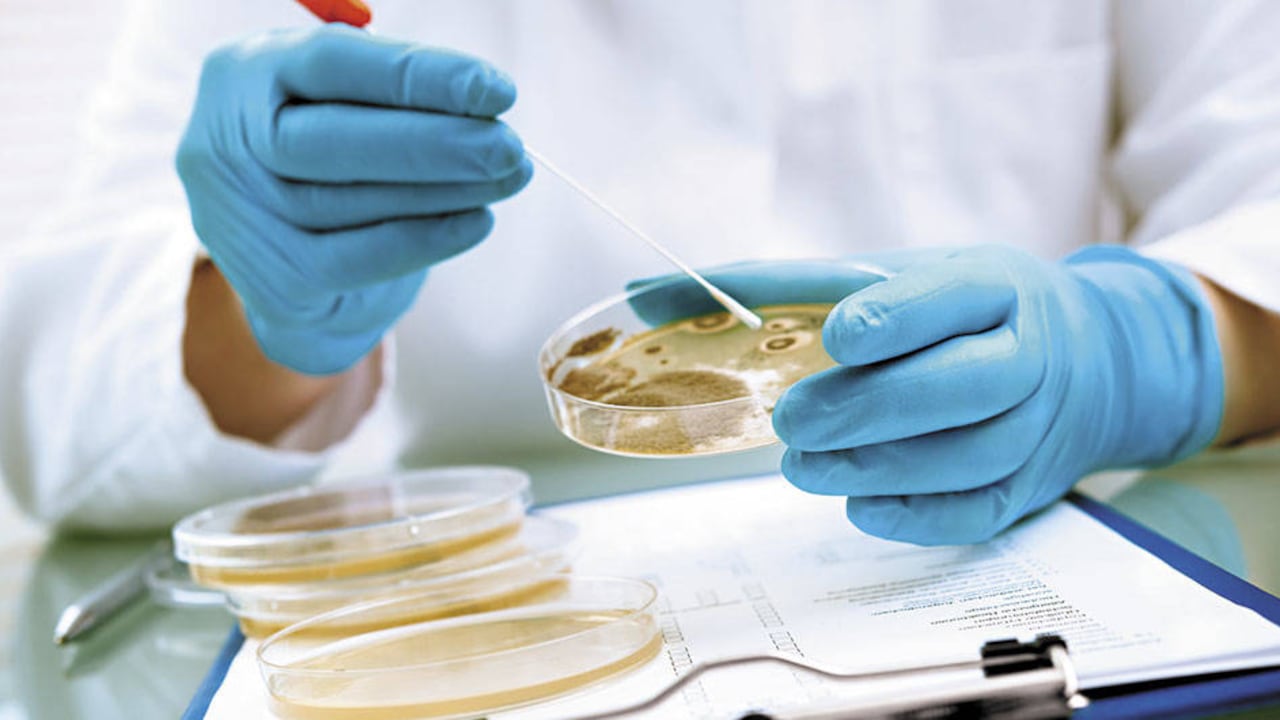

SALUD
Un hongo mortal podría ser la primera enfermedad del cambio climático
Se trata de un tipo de levadura llamada Candida auris descubierta hace diez años, que ataca a los pacientes más débiles en los hospitales. Esta y otras noticias importantes de ciencia y salud de la semana.
Un estudio publicado esta semana por la Sociedad Estadounidense de Microbiología afirma que un nuevo hongo, resistente a los medicamentos, podría ser la primera enfermedad provocada por el cambio climático. Se trata de un tipo de levadura llamada Candida auris descubierta hace diez años, que ataca a los pacientes más débiles en los hospitales. Lo curioso es que, desde entonces, apareció simultáneamente en varias partes del mundo, como India, Sudáfrica y Suramérica, y no en un solo sitio como ocurre comúnmente. Los científicos piensan que su proliferación obedece a algún cambio en el medioambiente de la Tierra, en este caso, un aumento gradual de la temperatura. Realizaron el trabajo investigadores de la Facultad de Salud Pública de la Universidad Johns Hopkins, Estados Unidos.
SALUD
Implante contra el VIH

Durante la conferencia internacional de sida, en Ciudad de México, la compañía Merck presentó un estudio acerca de una nueva droga que mostró efectividad para prevenir el contagio del VIH. Aunque el trabajo solo abarcó 12 personas, el medicamento logró proteger a los individuos durante 12 semanas. Se trata de un implante del tamaño de una cerilla que colocado en un brazo suministra pequeñas dosis del medicamento. Si en estudios clínicos más grandes los investigadores logran algo similar, sería un hito en la lucha contra esta enfermedad. La noticia resulta alentadora, pues 1,7 millones de personas contraen el virus al año en el mundo a pesar de las campañas de uso del condón y los esfuerzos por hallar una vacuna.
INVESTIGACIÓN
Talento o suerte

Muchos se preguntan si los éxitos en la vida, el amor y el juego resultan del talento o de la suerte. Un estudio realizado en Italia demostró que la respuesta depende de las circunstancias de cada quien. Los exitosos tienden a creer que obtuvieron sus logros por su propio esfuerzo, incluso en situaciones determinadas por el azar. Para demostrarlo, Mauricio Bucca, investigador del Instituto Universitario Europeo, creó una versión del juego President ajustada para no requerir ningún talento: siempre el primer participante ganaría la ronda. Reclutaron a 1.000 personas a las que les dieron 2,50 dólares por intervenir y un bono de 5 por cada jugada ganadora. Al final, los triunfadores tuvieron más probabilidades que los perdedores de decir que el juego era justo y que el éxito de ellos se debía a su talento, aunque era claro que no se requería de este para ganar. Según Bucca, en la vida real estas circunstancias –ser ganador o perdedor– podrían determinar a qué atribuyen las personas el éxito.
SEXUALIDAD
¿Por qué ven porno?

Muchas personas se preguntan la razón para que su media naranja vea pornografía si tiene una relación estable. Los psicólogos Colin Hesse y Kory Floyd, de las universidades de Oregon y Arizona, respectivamente, se plantearon esa cuestión en un reciente artículo de la revista Journal of Social and Personal Relationships. Según los autores, este comportamiento se explica desde la teoría del intercambio afectivo, que dice que todos los seres humanos necesitan interacciones con otros, con o sin contacto físico. Cuando estas no se dan en la vida real, la gente tiende a buscar sustitutos que pueden ser reales o ideales. De esta forma, las personas usarían la pornografía como un mecanismo para enfrentar la soledad afectiva.
CIFRA

4 de cada 10 colombianos sufrieron algún tipo de maltrato físico, psicológico o sexual cuando eran menores de edad. Así lo reveló la primera Encuesta de Violencia contra Niños, Niñas y Adolescentes, presentada por el Ministerio de Salud el lunes pasado.